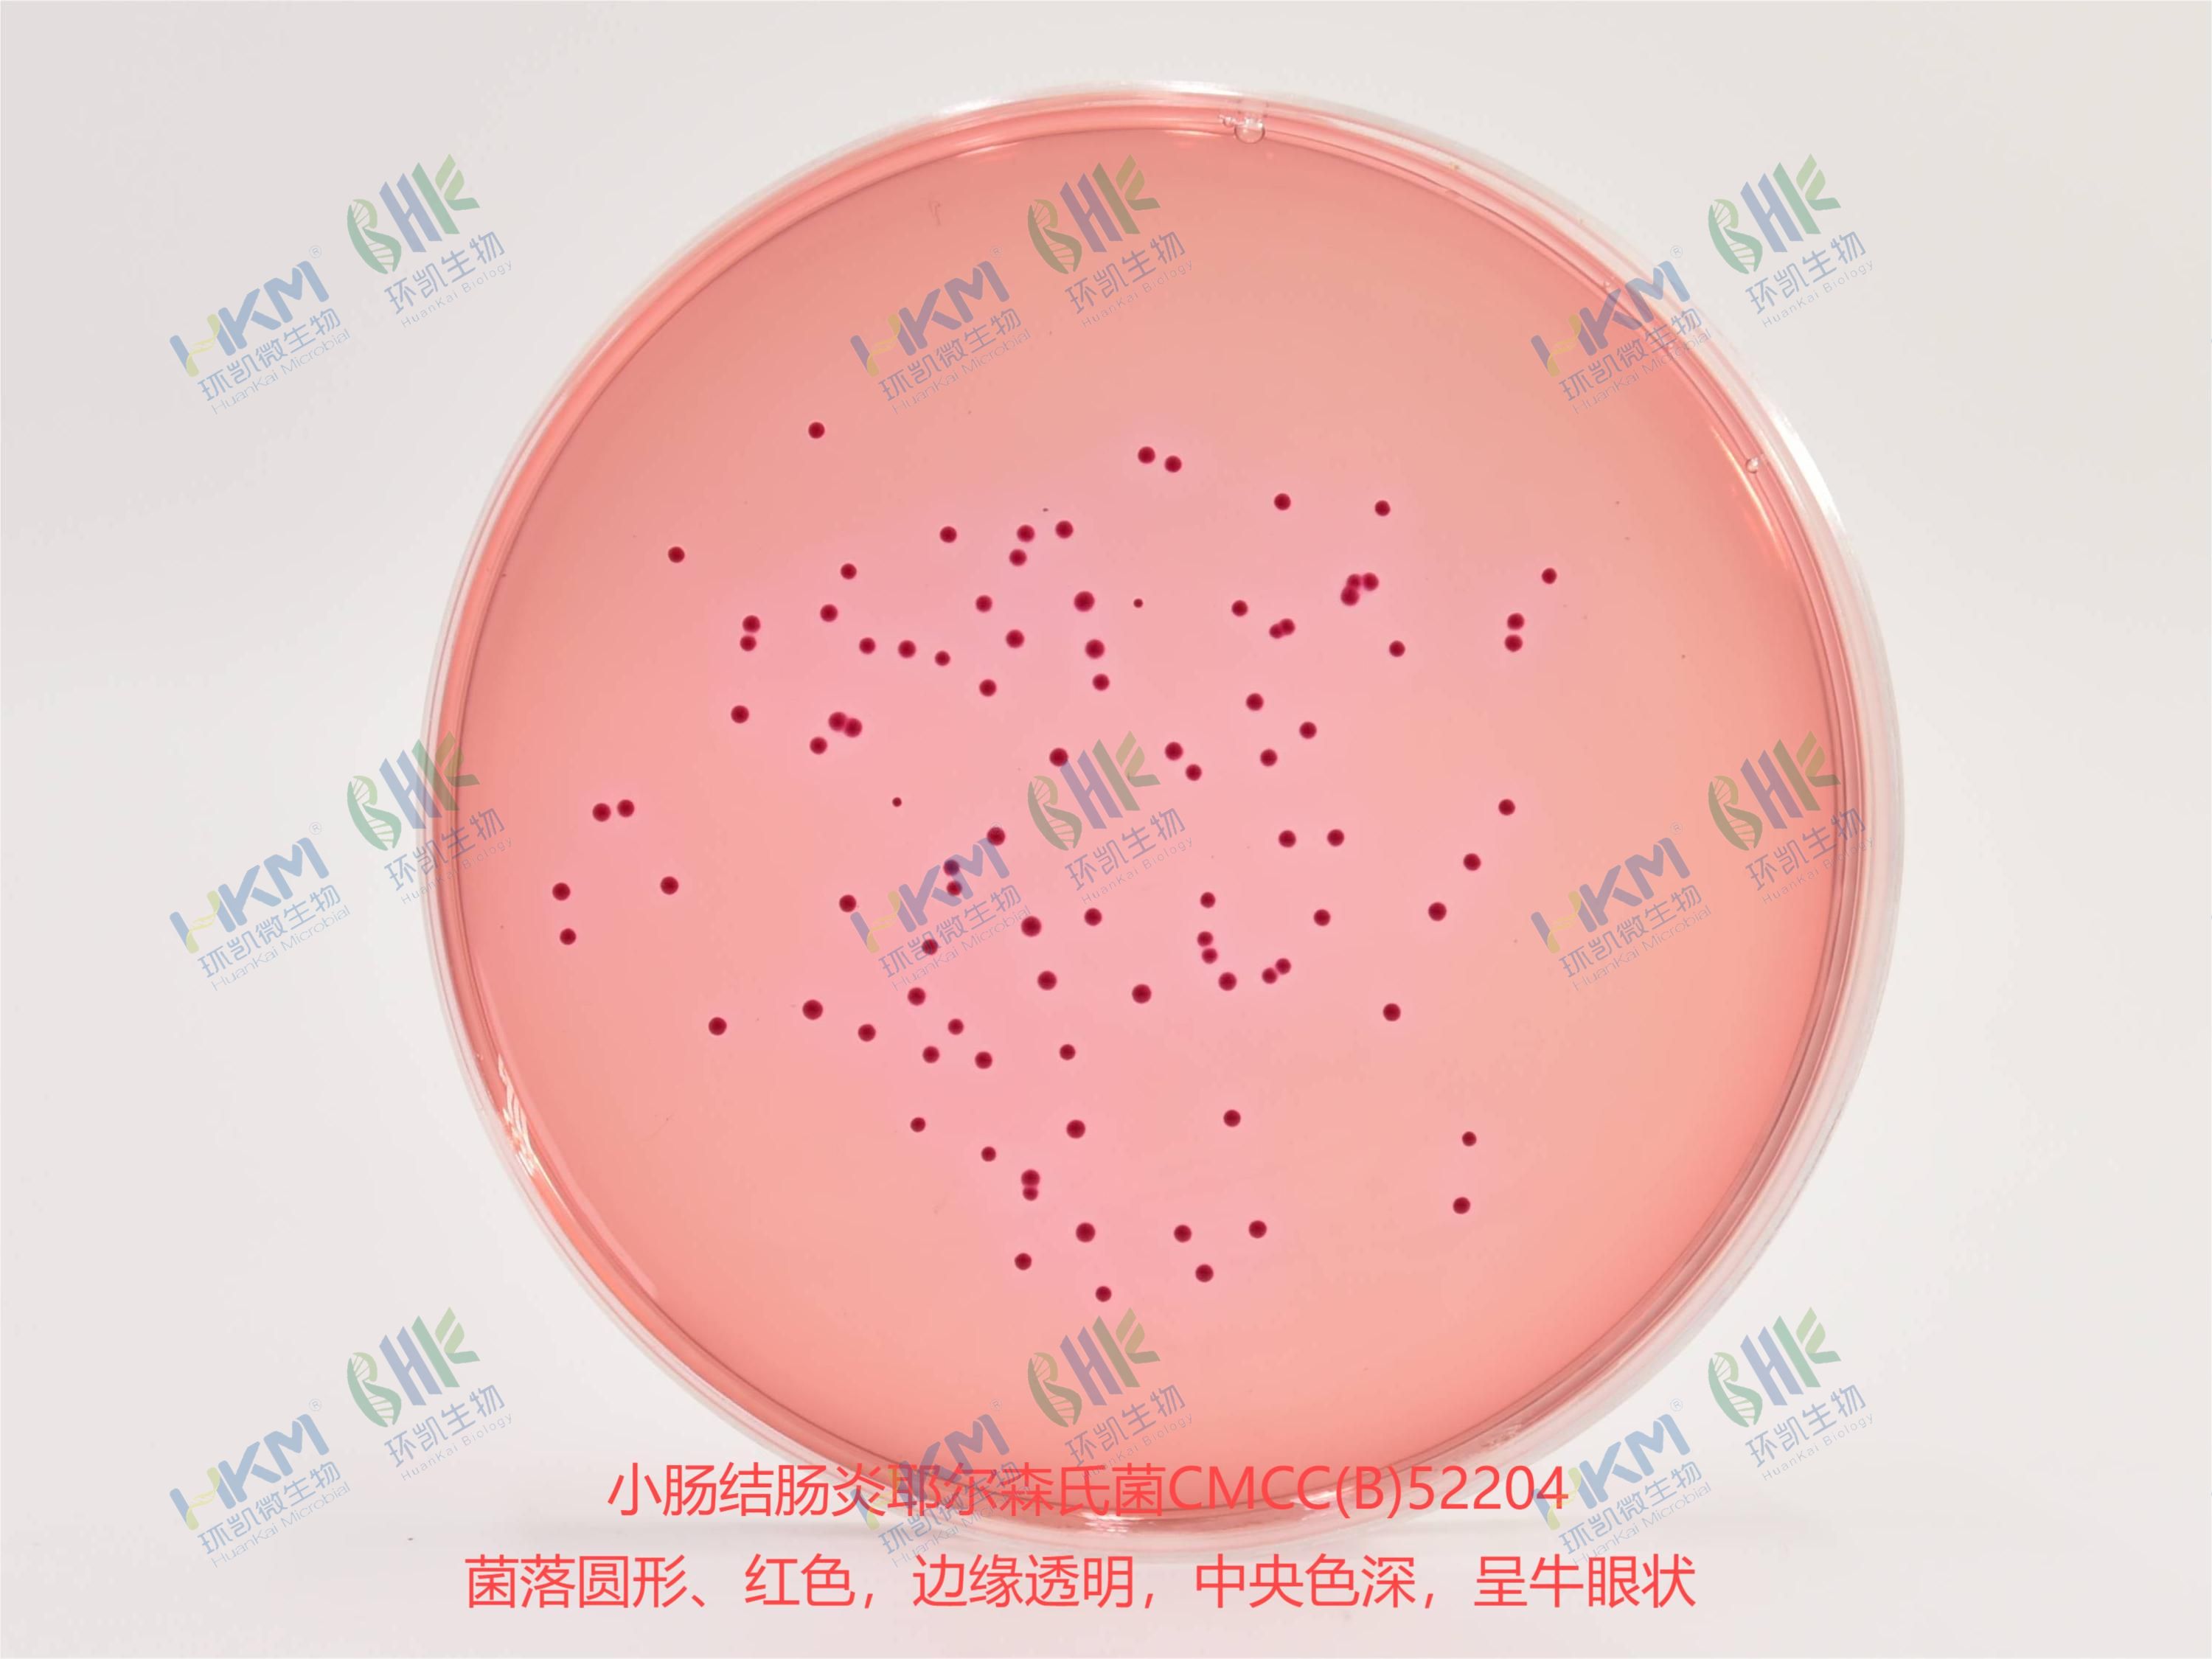
小腸結(jié)腸炎耶爾森氏菌CMCC(B)52204 小腸結(jié)腸炎耶爾森氏菌CMCC(B)52204

產(chǎn)品名稱:CIN-1培養(yǎng)基基礎(chǔ)
英文名稱:CIN-1 Medium Base
產(chǎn)品編號(hào)與包裝規(guī)格:
| 產(chǎn)品編號(hào) | 產(chǎn)品類型 | 包裝規(guī)格 |
|---|---|---|
| 029910 | 干粉 | 250g/瓶 |
產(chǎn)品用途:用于小腸結(jié)腸炎耶爾森氏菌的選擇性分離和培養(yǎng)。
檢驗(yàn)原理:胰胨和酵母浸膏提供氮源和微量元素;甘露醇為可發(fā)酵糖;去氧膽酸鈉和結(jié)晶紫抑制革蘭氏陽(yáng)性菌;中性紅是pH指示劑;瓊脂是培養(yǎng)基的凝固劑。
CIN-1培養(yǎng)基基礎(chǔ)配方成分:
| 配方(每升) | 含量 |
|---|---|
| 胰胨 | 20.0g |
| 酵母浸膏 | 2.0g |
| 甘露醇 | 20.0g |
| 氯化鈉 | 1.0g |
| 去氧膽酸鈉 | 2.0g |
| 硫酸鎂(MgSO4.7H2O) | 0.01g |
| 中性紅 | 0.03g |
| 結(jié)晶紫 | 0.001g |
| 瓊脂 | 12.0g |
| 最終pH 7.5±0.2 | |
使用方法:稱取本品57g,加入蒸餾水或去離子水1L,攪拌加熱煮沸至完全溶解,分裝三角瓶,121℃高壓滅菌15分鐘。冷卻至80℃左右,每100mL基礎(chǔ)培養(yǎng)基加入配套試劑A 1支(SR0250)(試劑A:0.04%二苯醚1mL),充分混勻。冷至45℃左右時(shí),加入配套試劑B 1支(SR0250)(試劑B:0.25mg新生霉素、1.5mg頭孢菌素和0.1g氯化鍶,用1mL無(wú)菌生理鹽水溶解),混合后傾注平板。
CIN-1培養(yǎng)基質(zhì)量控制(下列質(zhì)控菌株接種后于26±1℃培養(yǎng)48h,觀察結(jié)果如下表:):
| 指標(biāo) | 質(zhì)控菌株及編號(hào) | 標(biāo)準(zhǔn)值 | 特征性反應(yīng) |
|---|---|---|---|
| 生長(zhǎng)率 | 小腸結(jié)腸炎耶爾森氏菌CMCC(B)52204 | PR≥0.5 | 菌落圓形、紅色,邊緣透明,中央色深,呈牛眼狀 |
| 選擇性 | 大腸埃希氏菌ATCC25922 | G≤1 | —— |
| 糞腸球菌ATCC29212 | —— |
儲(chǔ)存條件與保質(zhì)期:貯存于避光、干燥處,用后立即旋緊瓶蓋;貯存期三年。
注意事項(xiàng):稱量時(shí)注意粉塵,佩戴口罩操作以避免引起呼吸道系統(tǒng)不適。干粉培養(yǎng)基使用后立即旋緊瓶蓋,避免吸潮結(jié)塊。貯存于避光、干燥處。未開封產(chǎn)品保質(zhì)期三年。開封后根據(jù)存放條件的不同保質(zhì)時(shí)間存在一定的差異。
參考文獻(xiàn):GB 4789.8-2016 中華人民共和國(guó)國(guó)家標(biāo)準(zhǔn) 食品衛(wèi)生微生物學(xué)檢驗(yàn) 小腸結(jié)腸炎耶爾森氏菌檢驗(yàn)
